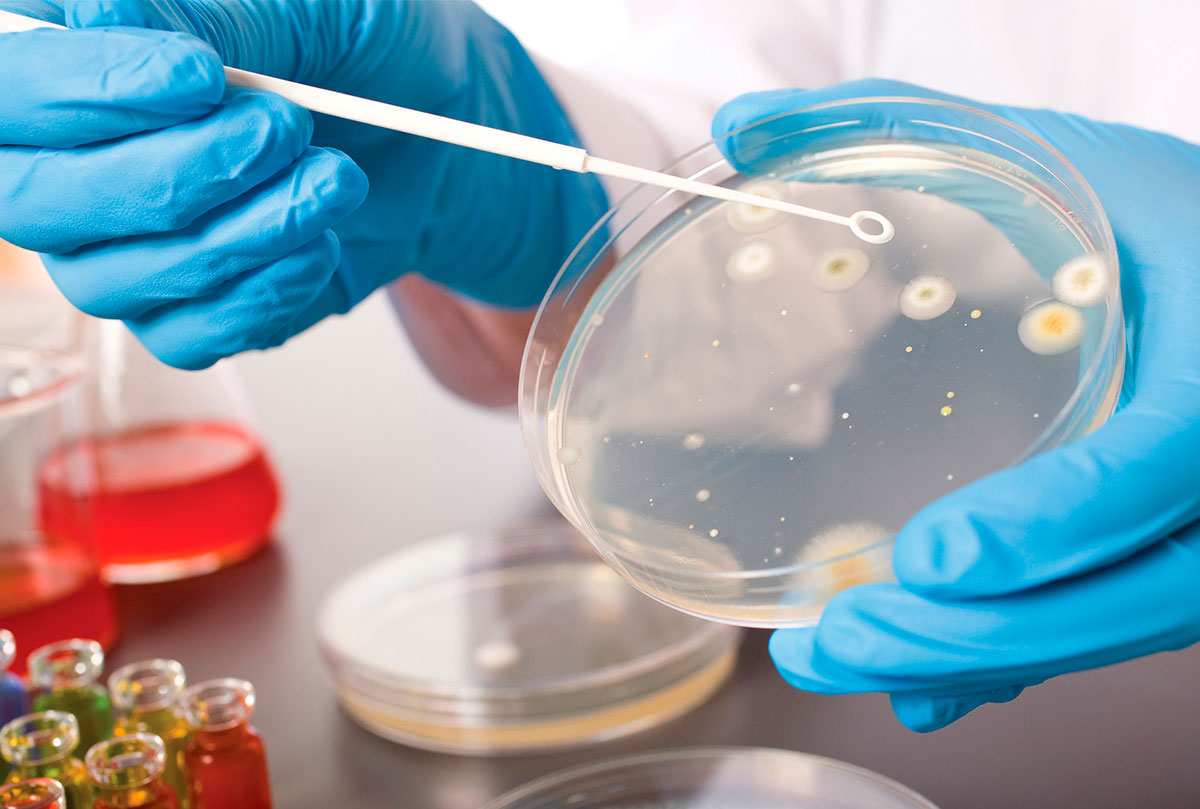

Микробиология
Клиническая микробиология - раздел медицинской микробиологии, изучающий взаимоотношения, складывающиеся между организмом и микробами в норме, при патологии, в динамике воспалительного процесса с учетом проводимой терапии до констатации клиницистом состояния клинического или полного выздоровления.

